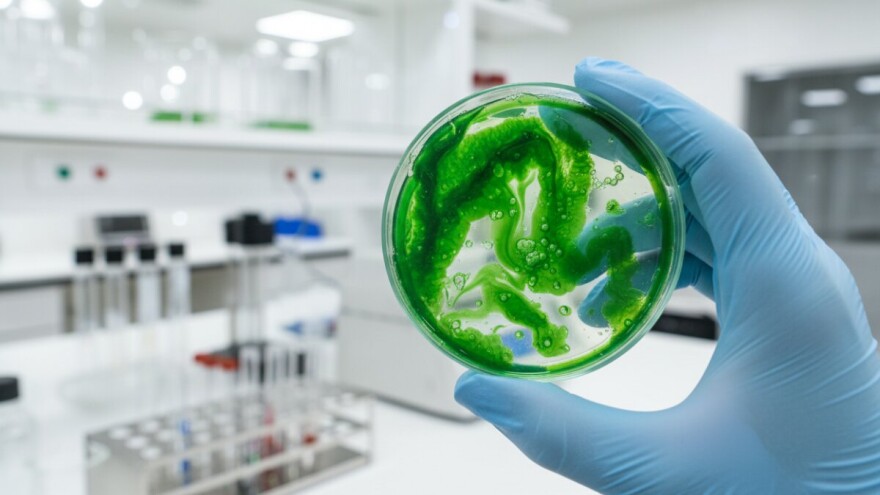
Nanotehnologija u prehrambenoj industriji

Europski parlament je izglasao regulativu o tzv. novoj hrani koja uređuje stavljanje na tržište prehrambenih proizvoda dobivenih npr. nanotehnologijom ili inovativnim uzgojem. Novi propisi će urediti i uvoz te prodaju egzotične hrane poput kukaca i algi.
"Ovom regulativom bi se trebala podići razina zaštite zdravlja potrošača i urediti funkcioniranje unutarnjeg tržišta. Njome će biti obuhvaćeni svi prehrambeni proizvodi koji nisu bili prisutni na tržištu EU prije 1997. godine. Ukratko, ako građani baš žele jesti skakavce, egzotične bobice i slično, ti proizvodi moraju biti zdravstveno ispravni i sigurni, ali i odobreni po ujednačenoj proceduri. Pa tko voli nek' izvoli", kazala je hrvatska europarlamentarka Biljana Borzan.
Bez štetnih posljedica najmanje 25 godina
Da bi neka egzotična hrana dobila odobrenje EU, uvoznik će morati dokazati da se ona u zemlji porijekla bez štetnih posljedica konzumira najmanje 25 godina. Do sada su među državama članicama postojale značajne razlike u sustavu odobrenja novih prehrambenih proizvoda, što je stvaralo probleme poljoprivrednicima i poduzetnicima. Nova regulativa uvodi red i ujednačuje procedure kako bi se olakšalo poslovanje i poticale inovacije u prehrambenoj industriji.
Zastupnica iz Hrvatske je podnijela nekoliko amandmana na prijedlog regulative kojima je, između ostalog, tražila da svim zainteresiranim bude dostupna lista zahtjeva za tržišno odobrenje nove hrane od strane Europske komisije.
Klonirano meso regulirat će se posebnom direktivom
"Kolege su podržali moje amandmane jer smatraju da davanje dozvola za stavljanje novih i inovativnih prehrambenih proizvoda na police europskih trgovina mora biti maksimalno transparentno. Potrošači i njihove organizacije, poduzetnici, poljoprivrednici i svi ostali zainteresirani će tako biti informirani o potencijalnim novim proizvodima na tržištu", objašnjava Borzan.
Zabrana prodaje kloniranog mesa je također trebala biti ugrađena u regulativu, no Europska komisija i Vijeće su to odbili s obrazloženjem da se donosi posebna direktiva o kloniranju kojom će se uvesti zabrana.
Nano-čestice u hrani
"Točno je da radimo na direktivi koja zabranjuje uzgoj i uvoz kloniranog mesa, no proći će barem par godina prije nego ona stupi na snagu. Postoji bojazan da bi netko u međuvremenu mogao zatražiti odobrenje kloniranog mesa kao nove hrane. U pravnom smislu rupa će postojati i trebalo bi je zatvoriti. Komisija tvrdi da proizvodna cijena jednog klona doseže dvadesetak tisuća eura, tako da se nikome ne isplati klonirati skupocjena goveda radi klanja," kazala je Borzan.
Još jedna točka oko koje su se lomila koplja su nano-čestice, odnosno označavanje hrane proizvedene nanotehnologijom. Trenutno je obvezno staviti na etiketu da hrana sadrži nano-čestice ako neki njen sastojak sadrži više od 50% takvih čestica. Parlament je tražio da se taj prag snizi na 10%, no Europska uprava za sigurnost hrane (EFSA) je kazala da trenutno ne raspolaže s tehnologijom kojom bi provodila takva ispitivanja. U regulativu je stoga ugrađena odgoda uvođenja nižeg praga, do trenutka kad ga EFSA bude mogla provoditi.